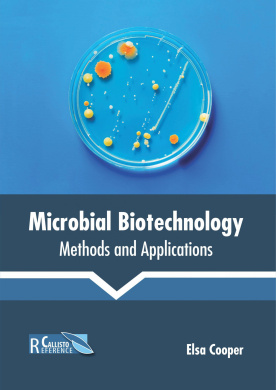
https://scientificbooks.net/sb/MPZsjXJX7MeqDxm78N.jpeg

-
-81%

Green Biotechnology and Allied Fields
0Original price was: $79.00.$15.00Current price is: $15.00.Green Biotechnology and Allied Fields, Joy Adam, 9781682863220
-
-77%

Handbook of Plant Cell Biotechnology
0Original price was: $31.00.$7.00Current price is: $7.00.Handbook of Plant Cell Biotechnology, Joy Adam, 9781682865828
-
-67%

Integrated Biotechnology: Principles and Practices
0Original price was: $48.00.$16.00Current price is: $16.00.Integrated Biotechnology: Principles and Practices, Joy Adam, 9781682863121
-
-75%

Introduction to Plant Reproduction
0Original price was: $73.00.$18.00Current price is: $18.00.Introduction to Plant Reproduction, Joy Adam, 9781682865835
-
-94%

Marine Enzymes Biotechnology
0Original price was: $113.00.$7.00Current price is: $7.00.Marine Enzymes Biotechnology, Joy Adam, 9781641167987
-
-42%
Microbial Biotechnology: Methods and Applications
0Original price was: $31.00.$18.00Current price is: $18.00.Microbial Biotechnology: Methods and Applications, Joy Adam, 9781641162227
-
-58%

Modern Insights in Biotechnology
0Original price was: $33.00.$14.00Current price is: $14.00.Modern Insights in Biotechnology, Joy Adam, 9781641161565
-
-75%

Natural Products in Chemical Biology
0Original price was: $65.00.$16.00Current price is: $16.00.Natural Products in Chemical Biology, Joy Adam, 9781641167956
-
-86%

New Insights Into Virus Bioinformatics
0Original price was: $58.00.$8.00Current price is: $8.00.New Insights Into Virus Bioinformatics, Joy Adam, 9781641167642
-
-89%

Plant Biotechnology: Genetics, Genomics and Breeding
0Original price was: $106.00.$12.00Current price is: $12.00.Plant Biotechnology: Genetics, Genomics and Breeding, Joy Adam, 9781682863985
-
-64%

Plant Biotechnology: Principles and Future Prospects
0Original price was: $39.00.$14.00Current price is: $14.00.Plant Biotechnology: Principles and Future Prospects, Joy Adam, 9781641161985
-
-84%

Plant Production: Natural Materials
0Original price was: $97.00.$16.00Current price is: $16.00.Plant Production: Natural Materials, Joy Adam, 9781682865019


